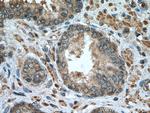
SQLE Antibody in Immunohistochemistry (Paraffin) (IHC (P))
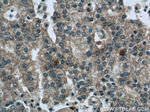
SQLE Antibody in Immunohistochemistry (Paraffin) (IHC (P))

Search
Proteintech
SQLE Polyclonal Antibody
{{$productOrderCtrl.translations['antibody.pdp.commerceCard.promotion.promotions']}}
{{$productOrderCtrl.translations['antibody.pdp.commerceCard.promotion.viewpromo']}}
{{$productOrderCtrl.translations['antibody.pdp.commerceCard.promotion.promocode']}}: {{promo.promoCode}} {{promo.promoTitle}} {{promo.promoDescription}}. {{$productOrderCtrl.translations['antibody.pdp.commerceCard.promotion.learnmore']}}
产品信息
12544-1-AP
种属反应
已发表种属
宿主/亚型
分类
类型
抗原
偶联物
形式
浓度
规格
纯化类型
保存液
内含物
保存条件
运输条件
产品详细信息
Immunogen sequence: SRDGRKVTV IERDLKEPDR IVGEFLQPGG YHVLKDLGLG DTVEGLDAQV VNGYMIHDQE SKSEVQIPYP LSENNQVQSG RAFHHGRFIM SLRKAAMAEP NAKFIEGVVL QLLEEDDVVM GVQYKDKETG DIKELHAPLT VVADGLFSKF RKSLVSNKVS VSSHFVGFLM KNAPQFKANH AELILANPSP VLIYQISSSE TRVLVDIRGE MPRNLREYMV EKIYPQIPDH LKEPFLEATD NSHLRSMPAS FLPPSSVKKR GVLLLGDAYN MRHPLTGGGM TVAFKDIKLW RKLLKGIPDL YDDAAIFEAK KSFYWARKTS HSFVVNILAQ ALYELFSATD DSLHQLRKAC FLYFKLGGEC VAGPVGL (143-508 aa encoded by BC017033 )
靶标信息
SQLE, also named as ERG1, SE and SM, belongs to the squalene monooxygenase family. It catalyzes the first oxygenation step in cholesterol synthesis, acting on squalene before cyclization into the basic steroid structure. SQLE may serve as a flux-controlling enzyme beyond 3-hydroxy-3-methylglutaryl-coenzyme A reductase (HMGR, considered as rate limiting). It is also post translationally regulated by cholesterol-dependent proteasomal degradation. The MW of SQLE is about 64 kDa.
仅用于科研。不用于诊断过程。未经明确授权不得转售。
生物信息学
蛋白别名: flavoprotein monooxygenase; FLJ30795; SE; Squalene epoxidase; Squalene monooxygenase; unnamed protein product
基因别名: AI323792; ERG1; SQLE
UniProt ID: (Human) Q14534, (Mouse) P52019, (Rat) P52020
Entrez Gene ID: (Human) 6713, (Mouse) 20775, (Rat) 29230